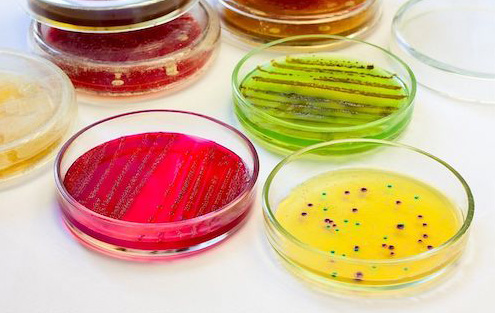

Herzlich Willkommen im Onlineportal
der Helios Apotheke Laakirchen!
Unser Anliegen ist es „Freundlichkeit und Kompetenz“
nach außen zu vermitteln.
Der Kunde steht für uns im Mittelpunkt,
deshalb versucht das Team der Helios Apotheke
sich ständig weiterzubilden, damit wir
Sie top beraten können.


anzupassen und auszubauen.
das Sortiment und die Serviceleistungen an Ihre Wünsche
anzupassen und auszubauen.
In unserer Apotheke finden Sie zahlreiche homöopathische Arzneien, Schüssler Salze, pflanzliche Heilmittel und ein breites Kosmetiksortiment inklusive Kosmetik-Eigenmarke, um Sie zu verwöhnen. Außerdem hat die Helios Apotheke eine eigene Nahrungsergänzungsmittel-Linie mit dem Namen ESPRII geschaffen.

Natürlich bieten wir auch vielfältige Serviceleistungen an, wie zum Beispiel Arzneimittelneuverblisterung, Blutanalysen, Kompressionsstrumpfanpassung, Antlitzanalyse nach Dr. Schüssler und viele mehr. Nähere Informationen erhalten Sie gerne bei uns in der Apotheke.
Wir freuen uns Sie bei uns in der Apotheke bergrüßen zu dürfen.
Das Team der Helios Apotheke

Holen Sie sich jetzt die Jännerausgabe in Ihrer Helios Apotheke! Bleiben Sie am Ball und holen Sie sich den Informationsvorsprung.

Die einmalige ESPRII 10 zu 1 Tauschaktion von der nicht nur die Umwelt profitiert, sondern auch Sie!Ab sofort bedeutet Recycling

Liebe Kund*innen, es gibt eine Änderung: die Anmeldung zu den Covid-Schnelltests erfolgt ab sofort ONLINE
Adresse
-
Gmundner Strasse 32
4663 Laakirchen -
Telefon +43 (0) 7613-44999
Fax +43 (0) 7613-44999-22 - E-Mail info@helios-apotheke.at
Öffnungszeiten
Mo-Fr 08:00 – 18:00
Sa 08:00 – 12:30

